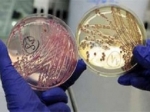
В Копенгагене вода заражена опасной бактерией В Копенгагене вода заражена опасной бактерией

Новости по категориям
Забыли пароль? Кликните здесь
|
20.08.2011
|
Богатейшие подростки планетыЖурнал People составил список самых высокооплачиваемых подростков в мире. Первое место в рейтинге досталось кумиру тинейджеров – Джастину Биберу, который заработал 53 млн долларов. |
|
20.08.2011
|
В Копенгагене вода заражена опасной бактериейВ водопроводной воде Копенгагена обнаружена смертельно опасная бактерия E-coli. Специалисты пытаются выявить источник заражения, но пока безуспешно. |
|
20.08.2011
|
Губернатором Тульской области стал В.ГруздевНа пост губернатора Тульской области назначили Владимира Груздева. Его кандидатуру, внесенную на рассмотрение региональной облдумы 11 августа, депутаты приняли на экстренном заседании. |
|
20.08.2011
|
В Петербурге хотят установить памятник интернетуВ Петербурге, возможно, установят памятник интернету. Соответствующая заявка подана в Комитет по градостроительству и архитектуре города от дизайн-студии Trendico. |
|
20.08.2011
|
"Газпром-медиа" намерен купить Comedy ClubНа российском телевидении в скором времени должна состояться крупнейшая сделка. Канал ТНТ, находящийся в составе холдинга "Газпром-медиа", купит контрольный пакет акций Comedy Club Production (ССР). |
|
20.08.2011
|
На Волжском бульваре в Москве появится скверВ районе Волжского бульвара в ЮВАО столицы появится сквер, данная идея поддержана мэром города С.Собяниным. По его распоряжению Москомархитектуры подготовит проект сквера, который разобьют на участке от улицы Окской до улицы Грайвороновской. |
|
20.08.2011
|
В Приморье введен запрет на купаниеВ районе Владивостока замечена стая акул. Власти ввели строжайший запрет на купание по всей территории края, в котором недавно дважды морская хищница напала на людей. Ученые считают, что жителей Приморья атаковала белая акула, которая появилась в акватории из-за потепления вод. |
|
20.08.2011
|
Баскетбольные команды Китая и США подрались, но затем помирилисьТоварищеская встреча между баскетбольными командами США и КНР в Пекине завершилась скандалом. Между командами во время матча завязалась драка. |
|
20.08.2011
|
Александр Поветкин сразится с КличкоБоксер-тяжеловес Александр Поветкин стремится к бою с Владимиром Кличко. По словам спортсмена из России, поединок пройдет после его титульного боя с Русланом Чагаевым (Узбекистан). |
|
20.08.2011
|
Hewlett Packard прекращает выпуск компьютерной техникиКомпания Hewlett Packard – известный американский производитель компьютерной техники – прекращает производство планшетов, компьютеров и смартфонов. В руководстве HP отмечают, что теперь компания сосредоточит усилия на выпуске программного обеспечения. |
|
20.08.2011
|
В Ливии мятежники захватили ЗлитанВ Ливии мятежники 19 августа смогли взять под контроль Злитан. Во время штурма оппозиционные силы лишились 30 человек, по некоторым данным, бои еще идут. Ранее войска захватили город Сурман, который находится всего в 70-ти км от Триполи – столицы Ливии. |
|
20.08.2011
|
Белоруссия заморозила совместные проекты с СШАВласти Белоруссии заявили, что приостанавливают реализацию совместных проектов с США по утилизации высокообогащенного урана. Как отметили в Министерстве иностранных дел страны, данное решение принято в связи с санкциями США, предпринятых в отношении Минска. |
|
20.08.2011
|
Футбольный клуб "Спартак" (Москва) намерен обратиться в УЕФА с жалобойФутбольный клуб "Спартак" (Москва) намерен обратиться в УЕФА с жалобой на полицию Польши, сотрудники которой применили противоправные действия к болельщикам из России в ходе матча раунда плей-офф Лиги Европы с "Легией" (Варшава). Встреча, состоявшаяся вечером 18 августа, окончилась со счетом 2:2. |
|
20.08.2011
|
Шарапова сыграет в финале со ЗвонаревойНеожиданной победой Марии Шараповой закончился российский дерби на теннисном супертурнире Женской теннисной ассоциации в Цинциннати. Неоднократная чемпионка турниров "Большого шлема" одержала победу над соотечественницей Светланой Кузнецовой, выиграв в 2-ух партиях со счетом 6:2 и 6:3. Так, Шарапова попала в четвертьфинал соревнований. |
|
20.08.2011
|
Бланка Власич примет участие в чемпионате мираЧемпионка мира по прыжкам в высоту Бланка Власич (Хорватия), получившая недавно травму, заявила, что будет защищать свое звание на мировом первенстве, которое стартует 27 августа в город Тэгу (Южная Корея). Ранее спортсменка сообщала, что пропустит турнир. |
|
20.08.2011
|
На дне Днепра найдены боеприпасыНа дне Днепра в Смоленске лежит свыше 1 тысячи снарядов и мин времен ВОВ, сообщает РИА Новости. |
|
20.08.2011
|
Купание в Японском море опасноВласти Приморского края призвали жителей и гостей региона не купаться в Японском море из-за акул. За последние дни в Хасанском районе Приморья совершены нападения на людей. Пострадавшими стали 25-летний мужчина и 16-летний подросток, которые на данный момент находятся в больнице. Мужчина лишился рук, а юноша получил травмы ног. |
|
20.08.2011
|
Минэкономразвития обяжет принимать к оплате картыМинэкономразвития РФ намерено сократить расчеты наличными в стране, для этого введя определенный лимит на сумму оплаты между юрлицами и гражданами. Кроме того, ведомство обяжет предприятия торговли и услуг принимать к оплате банковские карты. |